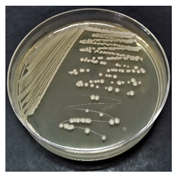
Sustainability 16 00563 i001
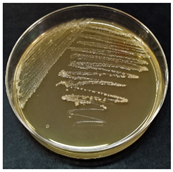
Sustainability 16 00563 i007

Abstract
The release of oil into the environment represents a pervasive problem stemming from oil exploration, accidents, transportation and releases from landfills, storage facilities or industrial plants. Compared to conventional and costly techniques, bioremediation is an attractive and promising alternative, as it can selectively degrade pollution without affecting the natural features of the site and the flora and fauna living there. In this study, the isolation, identification and characterization of autochthonous bacterial strains from a crude oil-contaminated soil sample was carried out under batch conditions over a period of 28 days. The initial colony forming units value for bacteria was 1.15 × 109/g of soil. The results show that the activity of bacteria was highest at a pH of 7.25. Based on morphology, biochemical tests and an analysis of MALDI TOF, isolated autochthonous bacterial species were identified as Bacillus megaterium, Bacillus licheniformis, Bacillus cereus and Pseudomonas chlororaphis. Since allochthonous bacteria are not highly efficient in a new environment due to their low adaptability and competition with indigenous microorganisms, these autochthonous microorganisms play a pivotal role in enhancing the bioremediation process on an applicable, industrial scale. This advancement aligns with the principles of sustainable development and the green economy, as purified soil is suitable for rational reuse in the environment.
1. Introduction
Soil is fundamental for life on Earth, playing a key role in food production, nutrient cycling, climate regulation and carbon sequestration, and it provides the foundation for industrial activities and infrastructure. It is a vital living ecosystem that offers a habitat to plants, animals and humans [1,2]. However, soil degradation, a significant global problem, exacerbated by petroleum hydrocarbon industry-related contamination, is posing a serious threat to living organisms [3,4]. The increasing global demand for energy has led to a surge in the consumption of oil and its products. Leaks and accidental spills can occur in all segments of the oil industry, from exploration and production, to transport, processing, storage and sale [3,5,6]. As a consequence, numerous sites—both new and historically polluted—require restoration to their original condition. The field of remediation technologies for soils contaminated with petroleum hydrocarbons is diverse, encompassing biological, chemical, physico-chemical and thermal technologies [7,8]. Although every remediation technology has its advantages and limitations, today bioremediation stands out as an efficient, environmentally friendly and cost-effective method [3,9]. Bioremediation technology leverages the metabolic capabilities of microorganisms to transform, reduce or eliminate contamination in the environment. The successful bioremediation of soil contaminated with crude oil and oil derivatives depends on meeting specific criteria. Bioremediation can be effective only where environmental conditions permit microbial growth and activity; most bioremediation systems run under aerobic conditions, with pH values of 6.5–8.0, a nutrient ratio of C:N:P = 100:10:1, a temperature range of 20–30 °C and a moisture content around 30% [10]. The limited bioavailability of hydrocarbons, due to low water solubility or interactions with the soil matrix, often impedes degradation efficiency. Therefore, the application of biosurfactant-producing microorganisms that also serve as hydrocarbon degraders is an effective and frequently applied bioremediation strategy [5,10,11,12]. Crude oil is a complex mixture of more than 1000 different compounds, primarily composed of hydrocarbons [13]. The efficiency of the biodegradation of hydrocarbons depends on their structure, with the general rule that the rate of degradation decreases with increasing complexity of the structure [14,15]. The successful biodegradation of all hydrocarbons requires the synergistic action of a microbial consortium, as each bacterial strain can degrade a specific group of molecules [15,16,17]. Microorganisms exposed to oil contamination adapt, exhibiting higher biodegradation rates than those in uncontaminated sites [11,12,18]. In clean, unpolluted sites, microorganisms capable of degrading petroleum hydrocarbons constitute less than 1% of the microbial community. This percentage rises to 10% in oil-contaminated locations and even up to 90% in some extreme cases [19]. Hydrocarbon degraders have developed adaptive mechanisms for survival in an environment contaminated by crude oil, such as the ability to emulsify and metabolize hydrocarbons, the activation of DNA repairing mechanisms, the production of the molecules involved in the mechanisms of quorum sensing and biofilms and the regulation of efflux pumps and pores to control the concentration of hydrocarbons within a cell [6]. The concept of inoculating the soil with hydrocarbon-utilizing microbial strains in order to increase the efficiency of the process is commonly known as bioaugmentation. The successful application of bioaugmentation depends on the inoculum’s ability to adapt to specific biotic and abiotic conditions in contaminated soil. To overcome competition with indigenous microorganisms and the low adaptability of allochthonous bacteria, bioaugmentation with native strains isolated from the same contaminated environment is preferred [6,11,12,18]. The analysis and characterization of indigenous microorganisms are very important steps for efficient bioaugmentation, and today numerous techniques have been developed for the isolation and identification of microorganisms. Modern molecular techniques, like PCR, DNA sequencing and genome analysis, have been developed for the isolation and identification of microorganisms based on their genetic material. Although these techniques are more sensitive and provide deeper insight into the microbiological community of the soil, the traditional shaking culture method has advantages like familiarity and reliability, and it is generally more affordable and accessible compared to molecular techniques, which can require specialized equipment [20,21].
Regarding the mentioned findings, these indigenous hydrocarbon degraders represent an interesting solution for bioremediation processes. The aim of this study was to isolate and characterize autochthonous bacterial strains with a high capacity to degrade hydrocarbons from soils contaminated with oil and oil derivatives. These strains hold potential for improving the efficiency and sustainability of the industrial bioremediation process through bioaugmentation. To the best of our knowledge, this is the first screening of bacterial strains that are capable of surviving exposure to crude oil in Croatian soil.
2. Materials and Methods
2.1. Soil
The soil sample contaminated with crude oil used in this study was obtained from a Croatian company specializing in waste management and environmental protection. The contamination resulted from a sudden oil pipeline leakage. The leak occurred in early spring, subjecting the soil to varying temperatures (ranging from 5 °C to 20 °C) and moderate rainfall. Following the incident, the affected soil was excavated and transported to a designated remediation site. After one month, approximately 1 kg of the contaminated sample was collected in a sterile bottle and transferred to the laboratory, where it was stored at 4 °C prior to the experiment. Characterized as fine-grained, weakly bonded clayey silts, the analyzed soil exhibited an average calcium carbonate content of about 20% and a total petroleum hydrocarbon concentration of 10.9 g/kg. The contaminated soil was moist and dark brown in color and had a distinct petrol odor. Before the start of the experiment, the contaminated soil was well homogenized and crushed by stirring with a sterile spoon. A representative sample of 15 g was taken from the homogenized soil and used for further analysis.
2.2. Microbiological Analysis of Crude Oil-Contaminated Soil
For the microbiological analysis of the crude oil-contaminated soil, a suspension was prepared in a 300 mL Erlenmeyer flask with a glass stopper, containing 15 g of contaminated, well-homogenized soil and 135 mL of a mineral medium [22]. The experiment was conducted for 28 days with a rotary shaker (Heidolph unimax 1010, Heidolph incubator 1000; Schwabach, Germany) at 150 rpm and a temperature of 25 °C. Once a day, the Erlenmeyer flask was stirred without a glass stopper for 2 h at 180 rpm to create aerobic conditions and was covered with hydrophobic cotton plugs. During the experiment, an indirect determination of the total number of living cells (colony forming units, CFU) and a determination of the pH (pH electrode Sentix® 940, WTW, Multi 3430 with pH indicator paper, Macherey-Nagel) in the suspension sample were carried out on days 0, 7, 14, 21 and 28. All determinations were averages of triplicate samples. Before sampling and dilution preparation, the Erlenmeyer flask was stirred at 180 rpm for 15 min, except on day 0 when it was stirred for 30 min. Inoculated Petri dishes with nutrient agar (Biolife) were placed in a thermostat at 37 °C for 24–48 h.
2.3. Morphological and Biochemical Analyses
Following the incubation of the Petri dishes, microorganisms were isolated and purified using the streaking method. The inoculated Petri dishes were incubated at 37 °C for 24–48 h. After obtaining purified cultures of microorganisms, the cells were stained via Gram staining and Schaeffer–Fulton staining. To characterize the isolated oil-degrading bacteria, morphological (Olympus BX50, ZEN Blue 2.5; Tokyo, Japan) and biochemical characterization [23] (catalase, oxidase, nitrate reductase, API 20E and API 50CH tests (BioMérieux, North Ryde, NSW, Australia) were conducted.
2.4. MALDI-TOF MS Analysis
Matrix-assisted laser desorption/ionization time-of-flight mass spectrometry (MALDI-TOF MS) analysis was carried out for the identification of purified bacterial isolates. The Bruker protocol with ethanol/formic acid extraction was applied for MALDI-TOF MS sample preparation [24]. Mass spectra were generated using a microflex LT MALDI-TOF mass spectrometer (Bruker Daltonics, MALDI Biotyper Compass HT 5.1., database version 11; Bremen, Germany).
3. Results and Discussion
Due to the high toxicity of petroleum hydrocarbons, it is necessary to remediate soil contaminated with crude oil [25,26]. In order to apply bioremediation, it is important to identify and characterize naturally occurring microorganisms in the soil with the capability to degrade oil pollution. If the soil microflora lacks the ability to degrade oil pollution, the application of bioaugmentation or other remediation methods becomes necessary [5,16].
3.1. Microbiological Analysis of Soil Contaminated with Crude Oil
Soil contamination with crude oil elevates organic carbon content, resulting in a change in the C:N ratio, which leads to a reduction in the number of indigenous microorganisms and disrupts their diversity. Crude oil significantly affects soil moisture, pH, total organic carbon, total nitrogen, exchangeable potassium and enzyme activity, but also impermeability, hydrophobicity and porosity, which ultimately inhibits bacterial growth [14]. Most microorganisms cannot survive in this environment, but some bacterial strains have developed adaptive mechanisms. After the initial adaptation time to stress, they start to grow by breaking down the substrate [6]. Microorganisms with high hydrocarbon degradation capabilities play a key role in mitigating this ecological concern [19,27].
For the microbiological analysis of the crude oil-contaminated soil sample over a period of 28 days, the total number of viable microorganisms (CFU) was determined. Figure 1 graphically represents the results of log CFU/g of soil for bacteria. The CFU of bacteria is shown after 24 and 48 h since different bacteria have different generation times and growth rates [28]. The CFU of bacteria after 24 h of incubation was 6.45 × 107 and 1.34 × 108/g of soil for day 0 and day 7, respectively. After 7 days, the CFU decreased, and on day 28, it was 2.81 × 107/g of soil. Higher CFU values were achieved after 48 h of incubation, with 1.15 × 109 and 1.75 × 109/g of soil for day 0 and day 7, respectively, with a subsequent decreasing trend until day 21 followed by a slight increase on day 28. When comparing the CFU after 24 h of incubation to that after 48 h, there was a 16% lower CFU on day 0, a 14% lower CFU on day 7, a 7% lower CFU on day 14 and a 2% lower CFU on day 21 and day 28. After 48 h of incubation, the CFU value increased by 2% from day 0 to day 7 and then decreased by 12% on day 14. From day 14 to day 21, the CFU further decreased by 10% and then increased by 1.8% from day 21 to day 28. The total decrease in the CFU of bacteria from day 0 to day 28 was 16%. This decline can be attributed to the detrimental impact of crude oil on the cell membrane and/or shifts in the pH value [29]. Recognizing the pH value as a pivotal factor influencing microbial communities, changes in the CFU of microorganisms can be explained by variations in the pH value [29,30]. Changes in the CFU over time can also be related to hydrocarbon degradation. After the initial lower values, with the decomposition of the substrate and the decrease in the concentration of total petroleum hydrocarbons, the CFU number increased. After the depletion of the carbon source (petroleum hydrocarbons), the CFU number in the soil began to decrease [18,31]. The average standard deviation for all measurements was 2.73%.
Figure 1.
Changes in log CFU and pH for bacteria after incubation for soil contaminated with crude oil over a period of 28 days.
During the 28-day period, the pH value was monitored in a sample of soil contaminated with crude oil. Starting at a pH of 6.50 on day 0, it increased until day 21, reaching 8.25. Subsequently, it decreased on day 28 to a pH of 7.75. Furthermore, the dependence of the CFU on the pH value is shown in Figure 2. The highest bacterial number occurred at a pH value of 7.25, aligning with the optimal pH range of 5.5–8.0 [10]. The highest CFU value for bacteria after 48 h of incubation was 1.75 × 109/g of soil.
Figure 2.
Dependence of the log CFU value for bacterial cultures on the pH values for soil contaminated with crude oil.
3.2. Morphological and Biochemical Analysis of Microorganisms
In the identification of microbial cultures, the initial steps involve isolation and subsequent purification using the streaking technique. This process continues until purified individual colonies, or isolates, are obtained as a result. Determining colony morphology is one of the initial steps in the identification and characterization of microorganisms [32]. Macroscopic and microscopic observations were used to characterize the isolated strains. The characteristics of the isolated microbial colonies are presented in Table 1.
Table 1.
Morphological characteristics of isolated bacterial strains from crude oil-contaminated soil.
To further characterize and identify bacteria, a series of biochemical tests, including catalase, oxidase, nitrate reduction and API strip tests, were conducted. The results are presented in Table 2. The results of Test 1 indicate that all isolates tested positive in the catalase test, meaning they contained the catalase enzyme. Beyond its role in cell protection, catalase plays a crucial role in aerobic bioremediation processes. It produces water and oxygen, which are essential for the metabolism of aerobic microorganisms and the degradation of pollutants [33]. As stated before, the oxidase enzyme (Test 2) belongs to the group of oxidoreductase enzymes that catalyze oxidation reactions. The activation and incorporation of oxygen represent the first step in the degradation of oil pollution in the environment [30].
Table 2.
Results of biochemical tests for the isolates from crude oil-contaminated soil.
Isolates A and B showed negative results, whereas C and D exhibited positive results for the oxidase test. According to Test 3, only culture C showed positive results for the nitrate reduction test. The presence of the nitrate reductase enzyme is significant in the denitrification process, where denitrifying bacteria reduce nitrate (NO3−) to molecular nitrogen in four steps using four specific enzymes [34]. The isolates showed enzymatic activity with specific substrates in the API strips (Table 2, Tests 4–40). However, satisfactory identification percentages were not achieved for any of the isolates based on the conducted tests. Potential reasons include insufficiently purified cultures, the API strip’s limitations and variations between wild and standard cultures [35]. The examination of the β-galactosidase enzyme via the hydrolysis of the o-nitrophenyl-β-D-galactopyranoside substrate (Test 4) yielded a positive result for isolates A and B. The hydrolysis of the o-nitrophenyl-β-D-galactopyranoside substrate by β-galactosidase is crucial, as it is also involved in the hydrolysis of lactose during the synthesis of galactooligosaccharides, which is characteristic for bacteria of the genus Bacillus [36,37]. Furthermore, all isolates yielded a positive result in Tests 5–7, indicating the presence of the enzymes arginine dihydrolase and tryptophan deaminase and the utilization of trisodium citrate as the sole carbon source. A positive result was obtained in Test 8 for isolate B, indicating the production of indole. Test 9 was positive for all tested isolates, showcasing the formation of acetoin from pyruvate with the help of the enzymes α-acetolactate synthase and α-acetolactate decarboxylase, characteristic of the genus Bacillus. In contrast, bacteria from the genus Pseudomonas are known for the degradation of acetoin [38,39]. Isolates A, B and C tested positive for Tests 30 and 31, indicating the fermentation of cellobiose and the hydrolysis of maltose using the enzyme maltase, characteristic of bacteria belonging to the genus Bacillus [40].
3.3. MALDI-TOF Analysis
The MALDI-TOF MS analysis resulted in spectra (Figure 3), where the x-axis represents the mass-to-charge ratio (m/z) and the y-axis represents the intensity. Peaks in the spectra represent different masses, and the height of a peak signifies the intensity of the signal. Further data processing of the obtained mass spectrum is necessary before comparison or reference to database spectra. Various algorithms and databases are employed for comparison, sharing a common principle. Results are generated based on the number of matching peaks, producing a list of best matches with associated identification probabilities, ranging from highly probable to unreliable identification [41]. The output value of MALDI Biotyper, calculated by comparing the reference spectrum in the database to the spectrum obtained from the unknown sample (images 4.18–4.23), is represented by the logarithmic score (Log(score)). This value ranges from 0.00 to 3.00, representing the probability of correct sample identification. Log(score) can indeed range between 2.00 and 3.00, indicating high confidence in identification. Additionally, scores between 1.70 and 1.99 reflect low confidence, and scores from 0.00 to 1.69 indicate an impossibility of identifying the organism.
Figure 3.
MALDI-TOF mass spectra of the bacterial isolates (A–D) and identification results. Numbers in brackets represent identification score values.
For isolate A (Figure 3A), the identification was established as Bacillus megaterium with a Log(score) value of 2.03, indicating a high level of confidence in the identification. Bacillus megaterium is the largest species within the genus Bacillus, with a length that can reach up to 5 μm. It is a Gram-positive, rod-shaped bacterium (Table 1) typically observed in pairs or chains. It is a spore-forming bacterium (Table 1) with subterminal and terminal spores with an elliptical or round shape. It can grow at temperatures ranging from 3 to 45 °C, with an optimal temperature of 30 °C. The optimal pH range for its growth falls between 6 and 7 [42]. Bacillus megaterium holds substantial significance in biotechnology and is applied in bioremediation processes to clean up soil contaminated with petroleum hydrocarbons. Previous research has demonstrated the potential of Bacillus megaterium to degrade petroleum hydrocarbons in soil. One study showed a degradation rate of 99.32% for petroleum hydrocarbons in soil over 100 days [43]. Additionally, another study investigated the degradation of 1%, 4% and 10% concentrations of 2T engine oil, resulting in degradation rates of 90.09%, 59.60% and 18.35%, respectively, after 14 days [44].
Isolate B (Table 1) was identified as Bacillus licheniformis (Figure 3B) with a Log(score) result of 2.09, indicating a high level of confidence in the identification. Bacillus licheniformis is a Gram-positive, rod-shaped (Table 1) and facultative anaerobic bacterium. It can exist individually, in pairs or in chains, and it is known for its spore-forming capability (Table 1), producing elliptical and cylindrical paracentral or subterminal spores. Bacillus licheniformis forms colonies with irregular or round shapes, which can appear diverse and resemble a mixed culture. The bacterium exhibits growth across a temperature range of 15 to 55 °C, with an optimal pH range of 5.7 to 6.8 [42]. Similar to Bacillus megaterium, Bacillus licheniformis possesses the ability to degrade petroleum hydrocarbons in soil. Studies have reported a degradation rate of 66% in crude oil after 14 days [45] and a degradation rate of 60% after 7 days when supplemented with nanoparticles and biosurfactants [46]. Bacillus licheniformis produces the biosurfactant lichenysin, a lipopeptide utilized in the bioremediation of oil-contaminated soil by reducing surface tension. Concentrations of 10–60 mg/L can decrease the surface tension to 10−2 mN/m [47].
Isolate C (Table 1) was identified as the bacterium Bacillus cereus (Figure 3C) with a Log(score) result of 2.03, indicating a high level of identification reliability. Bacillus cereus is a Gram-positive, facultative anaerobic, rod-shaped bacterium (Figure 3), existing individually, in pairs or in long chains. Similar to the previously discussed bacteria, it is sporogenic and forms elliptical, sometimes cylindrical, subterminal or paracentral spores. It grows at temperatures ranging from 10 to 45 °C, with an optimal temperature of 37 °C [37]. The optimal pH range for its growth is between 4.9 and 9.3 [48]. Bacillus cereus is commonly used in the bioremediation of soil contaminated with oil. Research has indicated its capability to degrade crude oil by 60–80% after 20 days and by 40% after 7 days [49,50].
Isolate D was identified as the bacterium Pseudomonas chlororaphis with a Log(score) value of 2.04, indicating high identification reliability. This represents the best match of the unknown sample with the reference microorganism spectrum (Table 1, Figure 3D). Pseudomonas chlororaphis belongs to the Pseudomonas fluorescens group. It is a Gram-negative, non-sporulating, rod-shaped bacteria (Table 1). It grows at temperatures ranging from 4 to 32 °C, with an optimal temperature for growth between 25 and 30 °C. The optimal pH range for growth is 7–8 [51]. Although the application of bacteria from the Pseudomonas fluorescens group in the bioremediation of oil-contaminated soil has not been extensively explored, there are some studies indicating its potential application [52,53].
The Pseudomonas and Bacillus genera have the ability to generate numerous enzymes, including catechol 1,2 dioxygenase, alkane 1-monooxygenase and long-chain alkane monooxygenase, which are responsible for the transformation and metabolism of petroleum hydrocarbons, suggesting their potential use in the environmental restoration of soils polluted with petroleum and its derivatives [6,54]. A microbiome adapted to an oil-contaminated environment may be a niche for the application of these bacteria in controlled trials.
Table 3 shows research on the isolated microorganisms exposed to crude oil and oil derivatives and their ability to survive in contaminated environments. These isolates, obtained from environmental samples such as contaminated soil, water or sludge, highlight the significant potential of microbial strains belonging to the Bacillus and Pseudomonas genera for effective soil bioremediation.
Table 3.
Microorganisms for bioremediation of oil contamination.
4. Conclusions
In conclusion, this study represents the scientific contribution of isolating and characterizing autochthonous bacterial strains from crude oil-contaminated soil. The CFU values for bacteria ranged from an initial value of 1.15 × 109/g of soil to a final CFU value of 4.00 × 107/g of soil after 28 days, a decrease that occurred with changes in the pH values. The prevalent presence of Gram-positive spore-forming bacteria in the soil sample contaminated with crude oil was notable. Biochemical tests play a crucial role in determining the presence of specific enzymes produced by microorganisms that play a significant role in the biodegradation of hydrocarbons and in the identification of microorganisms. The isolated autochthonous bacterial species—Bacillus megaterium, Bacillus licheniformis, Bacillus cereus and Pseudomonas chlororaphis—emerge as promising tools for the renewal of environmental resources contaminated with petroleum hydrocarbons. Their demonstrated ability to survive in crude oil-contaminated soils and produce a diverse range of enzymes positions them as valuable assets for enhancing the efficiency of the bioremediation process. Autochthonous microbial cultures isolated from crude oil-contaminated soil are pivotal in achieving a level of bioremediation efficiency that allows for the rational reuse of remediated soil without introducing new chemicals into the environment, constructing specialized plants or negatively impacting other environmental components. This aligns with the principles of the United Nations Sustainable Development Goals, contributing to the realization of a green economy and sustainable development. This study represents a noteworthy contribution to sustainable land use and management practices.
Author Contributions
Conceptualization, M.Š.R. and M.V.D.; methodology, M.V.D.; formal analysis, M.V.D.; investigation, B.B., M.Š.R., N.T., I.Z. and M.V.D.; resources, B.B. and M.V.D.; writing—original draft preparation, B.B., M.Š.R., N.T. and M.V.D.; writing—review and editing, B.B., M.Š.R. and M.V.D., visualization, N.T., M.Š.R. and M.V.D.; supervision, M.V.D. All authors have read and agreed to the published version of the manuscript.
Funding
This research received no external funding.
Data Availability Statement
Data are contained within the article.
Conflicts of Interest
Author Barbara Bertović was employed by the company STSI—Integrirani Tehnički Servisi d.o.o. The remaining authors declare that the research was conducted in the absence of any commercial or financial relationships that could be construed as a potential conflict of interest.
References
- Lal, R.; Bouma, J.; Brevik, E.; Dawson, L.; Field, D.J.; Glaser, B.; Hatano, R.; Hartemink, A.E.; Kosaki, T.; Las-celles, B.; et al. Soils and Sustainable Development Goals of the United Nations: An In-ternational Union of Soil Sciences Perspective. Geoderma Reg. 2021, 25, e0039. [Google Scholar] [CrossRef]
- Lehmann, J.; Bossio, D.A.; Kögel-Knabner, I.; Rillig, M.C. The Concept and Future Prospects of Soil Health. Nat. Rev. Earth Environ. 2020, 1, 544–553. [Google Scholar] [CrossRef]
- Ossai, I.C.; Ahmed, A.; Hassan, A.; Hamid, F.S. Remediation of Soil and Water Contaminated with Petroleum Hydrocarbon: A Review. Environ. Technol. Innov. 2020, 17, 100526. [Google Scholar] [CrossRef]
- Mukjang, N.; Chitov, T.; Mhuantong, W.; Champreda, V.; Pathom-aree, W.; Sattayawat, P.; Bovonsombut, S. Bacterial Communities Associated with Crude Oil Bioremediation through Composting Approaches with Indigenous Bacterial Isolate. Life 2022, 12, 1712. [Google Scholar] [CrossRef]
- Koshlaf, E.; Ball, A.S. Soil Bioremediation Approaches for Petroleum Hydrocarbon Polluted Environments. AIMS Microbiol. 2017, 3, 25–49. [Google Scholar] [CrossRef]
- Pandolfo, E.; Barra Caracciolo, A.; Rolando, L. Recent Advances in Bacterial Degradation of Hydrocarbons. Water 2023, 15, 375. [Google Scholar] [CrossRef]
- Lim, M.W.; Von Lau, E.; Poh, P.E. A Comprehensive Guide of Remediation Technologies for Oil Contaminated Soil—Present Works and Future Directions. Mar. Pollut. Bull. 2016, 109, 14–45. [Google Scholar] [CrossRef]
- Mambwe, M.; Kalebaila, K.K.; Johnson, T. Remediation Technologies for Oil Contaminated Soil. Glob. J. Environ. Sci. Manag. 2021, 7, 419–438. [Google Scholar]
- Al-Dhabaan, F.A. Morphological, Biochemical and Molecular Identification of Petroleum Hydrocarbons Biodegradation Bacteria Isolated from Oil Polluted Soil in Dhahran, Saud Arabia. Saudi J. Biol. Sci. 2019, 26, 1247–1252. [Google Scholar] [CrossRef]
- Vidali, M. Bioremediation. An Overview. Pure Appl. Chem. 2001, 73, 1163–1172. [Google Scholar] [CrossRef]
- Łebkowska, M.; Zborowska, E.; Karwowska, E.; Miaśkiewicz-Peska, E.; Muszyński, A.; Tabernacka, A.; Naumczyk, J.; Jeczalik, M. Bioremediation of Soil Polluted with Fuels by Sequential Multiple Injection of Native Microorganisms: Field-Scale Processes in Poland. Ecol. Eng. 2011, 37, 1895–1900. [Google Scholar] [CrossRef]
- Szulc, A.; Ambrozewicz, D.; Sydow, M.; Ławniczak, Ł.; Piotrowska-Cyplik, A.; Marecik, R.; Chrzanowski, Ł. The Influence of Bioaugmentation and Biosurfactant Addition on Bioremediation Efficiency of Diesel-Oil Contaminated Soil: Feasibility during Field Studies. J. Environ. Manag. 2014, 132, 121–128. [Google Scholar] [CrossRef]
- Marigómez, I. Oil, Crude. In Encyclopedia of Toxicology, 3rd ed.; Wexler, P., Ed.; Academic Press: Cambridge, MA, USA, 2014; pp. 663–669. [Google Scholar]
- Sui, X.; Wang, X.; Li, Y.; Ji, H. Remediation of Petroleum-Contaminated Soils with Microbial and Microbial Combined Methods: Advances, Mechanisms and Challenges. Sustainability 2021, 13, 9267. [Google Scholar] [CrossRef]
- Varjani, S.J. Microbial Degradation of Petroleum Hydrocarbons. Bioresour. Technol. 2017, 223, 277–286. [Google Scholar] [CrossRef]
- Bidja Abena, M.T.; Li, T.; Shah, M.N.; Zhong, W. Biodegradation of Total Petroleum Hydrocarbons (TPH) in Highly Contaminated Soils by Natural Attenuation and Bioaugmentation. Chemosphere 2019, 234, 864–874. [Google Scholar] [CrossRef]
- Nwankwegu, A.S.; Onwosi, C.O. Bioremediation of Gasoline Contaminated Agricultural Soil by Bioaugmentation. Environ. Technol. Innov. 2017, 7, 1–11. [Google Scholar] [CrossRef]
- Koshlaf, E.; Shahsavari, E.; Aburto-Medina, A.; Taha, M.; Haleyur, N.; Makadia, T.H.; Morrison, P.D.; Ball, A.S. Bioremediation Potential of Diesel-Contaminated Libyan Soil. Ecotoxicol. Environ. Saf. 2016, 133, 297–305. [Google Scholar] [CrossRef]
- Atlas, R.M.; Bartha, R. Hydrocarbon Biodegradation and Oil Spill Bioremediation. In Advances in Microbial Ecology, 1st ed.; Marshall, K.C., Ed.; Springer: Boston, MA, USA, 1992; Volume 12, pp. 287–338. [Google Scholar]
- Rizzo, P.; Malerba, M.; Bucci, A.; Sanangelantoni, A.M.; Remelli, S.; Celico, F. Potential Enhancement of the In-Situ Bioremediation of Contaminated Sites through the Isolation and Screening of Bacterial Strains in Natural Hydrocarbon Springs. Water 2020, 12, 2090. [Google Scholar] [CrossRef]
- Wang, S.; Cheng, F.; Guo, S. Highly Efficient Screening and Optimal Combination of Functional Isolates for Bioremediation of Hydrocarbon-Polluted Soil. Environ. Res. 2023, 219, 115064. [Google Scholar] [CrossRef] [PubMed]
- APHA. Standard Methods for the Examination of Water and Wastewater; APHA: Washington, DC, USA, 2012. [Google Scholar]
- Leboffe, M.J.; Pierce, B.E. Microbiology: Laboratory Theory and Application, 2nd ed.; Morton Publishing Company: Englewood, CO, USA, 2012. [Google Scholar]
- Vuković Domanovac, M.; Šabić Runjavec, M.; Meštrović, E. Bioaugmentation Effect of Aeromonas Hydrophila and Pseudomonas Putida on Kinetics of Activated Sludge Process in Treating Pharmaceutical Industrial Wastewater. J. Chem. Technol. Biotechnol. 2019, 94, 2721–2728. [Google Scholar] [CrossRef]
- Kuppusamy, S.; Maddela, N.R.; Megharaj, M.; Venkateswarlu, K. Total Petroleum Hydrocarbons: Environmental Fate, Toxicity, and Remediation, 1st ed.; Springer International Publishing: Cham, Switzerland, 2019. [Google Scholar]
- Wang, L.; Cheng, Y.; Naidu, R.; Bowman, M. The Key Factors for the Fate and Transport of Petroleum Hydrocarbons in Soil with Related in/Ex Situ Measurement Methods: An Overview. Front. Environ. Sci. 2021, 9, 756404. [Google Scholar] [CrossRef]
- Abatenh, E.; Gizaw, B.; Tsegaye, Z.; Wassie, M. Application of microorganisms in bioremediation—Review. Environ. Microbiol. 2017, 1, 2–9. [Google Scholar]
- Maier, R.M. Bacterial Growth. In Environmental Microbiology, 2nd ed.; Maier, R.N., Pepper, I.L., Gerba, C.P., Eds.; Academic Press: Cambridge, MA, USA, 2009; pp. 37–54. [Google Scholar]
- Ujowundu, C.O.; Kalu, F.N.; Nwaoguikpe, R.N.; Kalu, O.I.; Ihejirika, C.E.; Nwosunjoku, E.C.; Okechukwu, R.I. Biochemical and Physical Characterization of Diesel Petroleum Contaminated Soil in Southeastern Nigeria. Res. J. Chem. Sci. 2011, 8, 57–62. [Google Scholar]
- Das, S.; Dash, H.R. Microbial Bioremediation: A Potential Tool for Restoration of Contaminated Areas. In Microbial Biodegradation and Bioremediation; Das, S., Ed.; Elsevier: Amsterdam, The Netherlands, 2014; pp. 2–21. [Google Scholar]
- Suja, F.; Rahim, F.; Taha, M.R.; Hambali, N.; Rizal Razali, M.; Khalid, A.; Hamzah, A. Effects of Local Microbial Bioaugmentation and Biostimulation on the Bioremediation of Total Petroleum Hydrocarbons (TPH) in Crude Oil Contaminated Soil Based on Laboratory and Field Observations. Int. Biodeterior. Biodegrad. 2014, 90, 115–122. [Google Scholar] [CrossRef]
- Barrow, G.I.; Feltham, R.K.A. Cowan and Steel’s Manual for the Identification of Medical Bacteria, 3rd ed.; Cambridge University Press: Cambridge, UK, 1993. [Google Scholar]
- Kaushal, J.; Mehandia, S.; Singh, G.; Raina, A.; Arya, S.K. Catalase Enzyme: Application in Bioremediation and Food Industry. Biocatal. Agric. Biotechnol. 2018, 16, 192–199. [Google Scholar] [CrossRef]
- Grgas, D.; Štefanac, T.; Galant, M.; Brozinčević, A.; Štrkalj, A.; Dragičević, T.L. Biološka denitrifikacija. Croat. J. Food Technol. Biotechnol. Nutr. 2021, 16, 28–34. [Google Scholar]
- Martinez-Urtaza, J.; Lozano-Leon, A.; Viña-Feas, A.; De Novoa, J.; Garcia-Martin, O. Differences in the API 20E Biochemical Patterns of Clinical and Environmental Vibrio Parahaemolyticus Isolates. FEMS Microbiol. Lett. 2006, 255, 75–81. [Google Scholar] [CrossRef] [PubMed][Green Version]
- Lee, B.H. Structure, function and applications of microbial β-galactosidase (lactase). In Carbohydrate-Active Enzymes, 1st ed.; Park, K.-H., Ed.; Woodhead Publishing: Sawston, UK, 2008; pp. 77–110. [Google Scholar]
- Sharma, N.; Sharma, N.; Sharma, S.; Sharma, P.; Devi, B. Identification, morphological, biochemical, and genetic characterization of microorganisms. In Basic Biotechniques for Bioprocess and Bioentrepreneurship, 1st ed.; Bhatt, A.K., Bhatia, R.K., Bhalla, T.C., Eds.; Academic Press: Cambridge, MA, USA, 2023; pp. 47–84. [Google Scholar]
- Härtig, E.; Jahn, D. Regulation of the anaerobic metabolism in Bacillus subtilis. In Advances in Microbial Physiology, 1st ed.; Poole, R.K., Ed.; Academic Press: Cambridge, MA, USA, 2012; Volume 61, pp. 195–216. [Google Scholar]
- Rajoka, M.I.; Malik, K.A. Cellulomonas. In Encyclopedia of Food Microbiology, 1st ed.; Batt, C.A., Robinson, R.K., Eds.; Academic Press: Cambridge, MA, USA, 1999; pp. 365–371. [Google Scholar]
- Tittsler, R.P.; Sandholzer, L.A.; Dentistry, R.; York, N. The Fermentation of cellobiose by bacteria. J. Bacteriol. 1936, 31, 301–307. [Google Scholar] [CrossRef]
- Randell, P. It’s a MALDI but it’s a Goodie: MALDI-TOF mass spectrometry for microbial identification. Thorax 2014, 69, 776–778. [Google Scholar] [CrossRef]
- Schleifer, K.-H. Phylum XIII. Firmicutes Gibbons and Murray 1978, 5 (Firmacutes [Sic] Gibbons and Murray 1978, 5). In Bergey’s Manual of Systematic Bacteriology, 2nd ed.; De Vos, P., Garrity, G.M., Jones, D., Krieg, N.R., Ludwig, W., Rainey, F.A., Schleifer, K.-H., Whitman, W.B., Eds.; Springer: New York, NY, USA, USA, 2009; Volume 3, pp. 19–1317. [Google Scholar]
- Kuri, M.L.; Roy, S. Biodegradation of Petroleum Oil by a Novel Bacillus megaterium Strain Isolated from Contaminated Soil of Neemrana, Alwar, Rajasthan, India. Int. J. Biotechnol. Bioeng. 2019, 10, 17–27. [Google Scholar]
- Yudono, B.; Said, M.; Sabaruddin; Napoleon, A.; Utami, M.B. Kinetics of Petroleum-Contaminated Soil Biodegraded by an Indigenous Bacteria Bacillus megaterium. Hayati 2010, 17, 155–160. [Google Scholar] [CrossRef]
- Khanpour-Alikelayeh, E.; Partovinia, A.; Talebi, A.; Kermanian, H. Investigation of Bacillus licheniformis in the Biodegradation of Iranian Heavy Crude Oil: A Two-Stage Sequential Approach Containing Factor-Screening and Optimization. Ecotoxicol. Environ. Saf. 2020, 205, 111103. [Google Scholar] [CrossRef] [PubMed]
- El-Sheshtawy, H.S.; Ahmed, W. Bioremediation of Crude Oil by Bacillus licheniformis in the Presence of Different Concentration Nanoparticles and Produced Biosurfactant. Int. J. Environ. Sci. Technol. 2017, 14, 1603–1614. [Google Scholar] [CrossRef]
- Karlapudi, A.P.; Venkateswarulu, T.C.; Tammineedi, J.; Kanumuri, L.; Ravuru, B.K.; Ramu Dirisala, V.; Kodali, V.P. Role of Biosurfactants in Bioremediation of Oil Pollution—A Review. Petroleum 2018, 4, 241–249. [Google Scholar] [CrossRef]
- Schneider, K.R.; Parish, M.E.; Goodrich, R.M.; Cookingham, T. Preventing Foodborne Illness: Bacillus cereus and Bacillus anthracis; University of Florida—IFAS Exension: Gainesville, FL, USA, 2017; pp. 1–5. [Google Scholar]
- Deng, Z.; Jiang, Y.; Chen, K.; Gao, F.; Liu, X. Petroleum Depletion Property and Microbial Community Shift After Bioremediation Using Bacillus Halotolerans T-04 and Bacillus cereus 1-1. Front. Microbiol. 2020, 11, 353. [Google Scholar] [CrossRef] [PubMed]
- Vinothini, C.; Sudhakar, S.; Ravikumar, R. Biodegradation of petroleum and crude oil by Pseudomonas putida and Bacillus cereus. Int. J. Curr. Microbiol. App. Sci. 2015, 4, 318–329. [Google Scholar]
- Scales, B.S.; Dickson, R.P.; Lipuma, J.J.; Huffnagle, G.B. Microbiology, Genomics, and Clinical Significance of the Pseudomonas fluorescens Species Complex, an Unappreciated Colonizer of Humans. Clin. Microbiol. Rev. 2014, 27, 927–948. [Google Scholar] [CrossRef]
- Gutiérrez, E.J.; Abraham, M.D.R.; Baltazar, J.C.; Vázquez, G.; Delgadillo, E.; Tirado, D. Pseudomonas fluorescens: A Bioaugmentation Strategy for Oil-Contaminated and Nutrient-Poor Soil. Int. J. Environ. Res. Public Health 2020, 17, 6959. [Google Scholar] [CrossRef]
- Barathi, S.; Vasudevan, N. Bioremediation of Crude Oil Contaminated Soil by Bioaugmentation of Pseudomonas Fluorescens NS1. J. Environ. Sci. Health A Toxic Hazard. Subst Environ. Eng. 2003, 38, 1857–1866. [Google Scholar] [CrossRef]
- Abdelhaleem, H.A.R.; Zein, H.S.; Azeiz, A.; Sharaf, A.N.; Abdelhadi, A.A. Identification and Characterization of Novel Bacterial Polyaromatic Hydrocarbon-Degrading Enzymes as Potential Tools for Cleaning up Hydrocarbon Pollutants from Different Environmental Sources. Environ. Toxicol. Pharmacol. 2019, 67, 108–116. [Google Scholar] [CrossRef]
- Liu, H.; Yang, G.; Jia, H.; Sun, B. Crude Oil Degradation by a Novel Strain Pseudomonas aeruginosa AQNU-1 Isolated from an Oil-Contaminated Lake Wetland. Processes 2022, 10, 307. [Google Scholar] [CrossRef]
- Annie, G.; Sheela, A.M.; Ilamathi, R. Fate of Crude Oil in Soil Treated with Pseudomonas putida Immobilized on Coconut Coirpith a Lowcost Biocarrier. Soil Sediment Contam. 2020, 29, 770–787. [Google Scholar] [CrossRef]
Disclaimer/Publisher’s Note: The statements, opinions and data contained in all publications are solely those of the individual author(s) and contributor(s) and not of MDPI and/or the editor(s). MDPI and/or the editor(s) disclaim responsibility for any injury to people or property resulting from any ideas, methods, instructions or products referred to in the content. |
© 2024 by the authors. Licensee MDPI, Basel, Switzerland. This article is an open access article distributed under the terms and conditions of the Creative Commons Attribution (CC BY) license (https://creativecommons.org/licenses/by/4.0/).